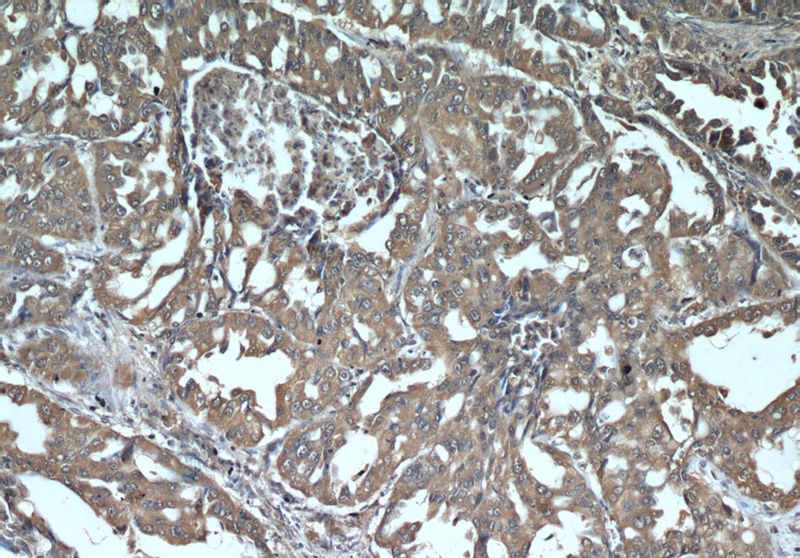
Immunohistochemical of paraffin-embedded human lung cancer using Catalog No:107277(IFITM3 antibody) at dilution of 1:50 (under 10x lens)

-
Product Name
IFITM3 antibody
- Documents
-
Description
IFITM3 Mouse Monoclonal antibody. Positive WB detected in Hela cells, human placenta tissue. Positive FC detected in HeLa cells. Positive IHC detected in human lung cancer tissue. Positive IF detected in HepG2 cells. Observed molecular weight by Western-blot: 14 kDa
-
Tested applications
ELISA, WB, IF, IHC, FC
-
Species reactivity
Human; other species not tested.
-
Alternative names
1 8U antibody; IFITM3 antibody; IP15 antibody
-
Isotype
Mouse IgG1
-
Preparation
This antibody was obtained by immunization of IFITM3 recombinant protein (Accession Number: NM_021034). Purification method: Protein G purified.
-
Clonality
Monoclonal
-
Formulation
PBS with 0.02% sodium azide and 50% glycerol pH 7.3.
-
Storage instructions
Store at -20℃. DO NOT ALIQUOT
-
Applications
Recommended Dilution:
WB: 1:500-1:5000
IHC: 1:20-1:200
IF: 1:10-1:100
-
Validations

HeLa cells were subjected to SDS PAGE followed by western blot with Catalog No:107277(IFITM3 antibody) at dilution of 1:1000
Immunohistochemical of paraffin-embedded human lung cancer using Catalog No:107277(IFITM3 antibody) at dilution of 1:50 (under 10x lens)

Immunofluorescent analysis of HepG2 cells, using IFITM3 antibody Catalog No: at 1:25 dilution and Rhodamine-labeled goat anti-mouse IgG (red).

1X10^6 HeLa cells were stained with 0.2ug IFITM2/3 antibody (Catalog No:107277, red) and control antibody (blue). Fixed with 90% MeOH blocked with 3% BSA (30 min). Alexa Fluor 488-congugated AffiniPure Goat Anti-Mouse IgG(H+L) with dilution 1:1000.
-
Background
IFITM3, also named as interferon-inducible protein 1-8U, belongs to the CD225 family. It is IFN-induced antiviral protein that mediates cellular innate immunity to at least three major human pathogens, namely influenza A H1N1 virus, West Nile virus (WNV), and dengue virus, by inhibiting the early steps of replication. IFITM3 is identified as interferon-induced cellular proteins that restrict infections by retroviruses and filoviruses and of influenza virus and flaviviruses, respectively. IFITM3, the most potent antiviral IFITM, was found to inhibit an uncharacterized early infectious event after VSV endocytosis, but before primary transcription of its viral genome. IFITM proteins are viral restriction factors that can inhibit infection mediated by the influenza A virus (IAV) hemagglutinin (HA) protein. They differentially restrict the entry of a broad range of enveloped viruses, and modulate cellular tropism independently of viral receptor expression. This antibody recognizes both IFITM2 and IFITM3.
-
References
- Xie M, Xuan B, Shan J. Human cytomegalovirus exploits interferon-induced transmembrane proteins to facilitate morphogenesis of the virion assembly compartment. Journal of virology. 89(6):3049-61. 2015.
Related Products / Services
Please note: All products are "FOR RESEARCH USE ONLY AND ARE NOT INTENDED FOR DIAGNOSTIC OR THERAPEUTIC USE"
